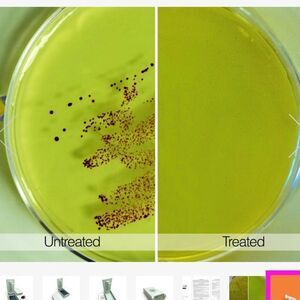
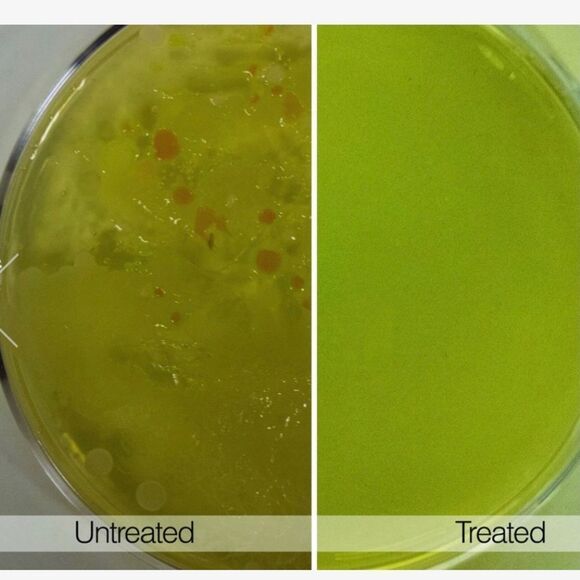
NWT Tech Candy UV Sanitizer in Light Mint - Picture 8 of 16
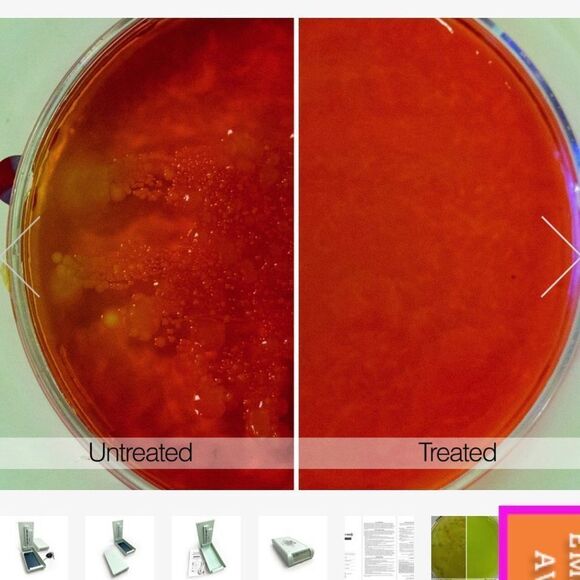
NWT Tech Candy UV Sanitizer in Light Mint - Picture 9 of 16

NWT Tech Candy UV Sanitizer in Light Mint
NWT
$27 $60
Size
Like and save for later
Add To Bundle
Tech Candy UV Sanitizer In Light Mint. Brand new in box.
This sanitizing bed kills up to 99% of Staph, E. Coli, Salmonella + other harmful bacteria in just minutes. UV-C light is frequently used in professional environments to sanitize and reduce the presence of bacteria and other germs.
Use the Tech Candy UV Sanitizer to reduce the number of germs on your everyday items that have a hard surface. Think hard, smooth items like cell phones or IDs that you handle more than you expect.
Color
Shipping/Discount
Trending Now
Find Similar Listings
Account is under Review
Comment posting is temporarily restricted. Our team will reach out to you shortly. To understand why, select
Learn More.